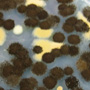
blackmold-thumb.jpg A type of black mold, Aspergillus niger, is commonly found in homes.

Success Stories

HIV is a leading cause of death worldwide. According to World Health Organization (WHO) data, in 2018, 37.9 million people including 1.7 million children lived with HIV globally and the disease claimed 770,000 lives.1 Another 1.7 million people became newly infected with HIV in 2018 alone.2
HIV has the ability to mutate and replicate itself in the presence of antiretroviral drugs which is called HIV drug resistance (HIVDR).3 Consequences of HIVDR include ineffective treatment for those beginning therapy, treatment failure for those on treatment, and spread of drug resistant HIV to newly infected persons.3, 4
CDC researchers developed a low-cost technology to rapidly detect HIV-1 drug resistance in plasma and dried blood spot (DBS) samples with 95.8% genotyping sensitivity. CDC’s partners have licensed, further developed, and incorporated the technology into a commercialized product.

Antineoplastic drugs, also known as anti-cancer drugs or chemotherapy, are used in the treatment of many types of cancer. Exposure of healthcare workers to antineoplastic drugs from contaminated surfaces and drug vials in hospitals and pharmacies is a continuing problem since the drugs can cause skin problems, birth defects, reproductive issues, and increased risk of various cancers.
CDC researchers at the National Institute for Occupational Safety and Health (NIOSH) developed technology to rapidly detect three commonly used antineoplastic drugs. (The technology is applicable to many types of antineoplastic drugs.) CDC initially developed the lateral flow immunoassay that allows sampling of surfaces to assess drug contamination. CDC NIOSH’s partner licensed, further developed, and incorporated the technology into a portable device. The resulting tool can analyze samples for doxorubicin and methotrexate (two common chemotherapy drugs) and provide reliable results in less than 10 minutes.

CDC’s National Center for Emerging and Zoonotic Infectious Diseases and Technology Transfer Office staff have transferred technology that employs a naturally-derived substance for controlling arthropod pests, such as mosquitoes, ticks, and fleas. The active ingredient, nootkatone, is found in Alaska yellow cedar trees (also known as the Nootka cypress), some herbs, and citrus fruits. Biologists in CDC’s Division of Vector-Borne Diseases have found nootkatone to be an effective repellent and insecticide for use against ticks and mosquitoes. Ticks and mosquitoes spread bacteria and viruses that can make people sick (for example, Lyme disease, West Nile virus disease).
Nootkatone appears to work differently compared to currently available insecticides and may be a valuable new option for fighting the growing problem of insecticide resistance in mosquitoes. It can be used both as a repellent on human skin or clothing to prevent bites and as an outdoor insecticide to kill insects and ticks. To expand available insect and tick repellent options, nootkatone could be formulated for use in soaps, sprays, and lotions.

Mosquitoes are responsible for spreading many viruses that can make people sick, including dengue, Zika, chikungunya, yellow fever, and more. CDC’s Autocidal Gravid Ovitrap (AGO) mosquito trap has been successfully used for mosquito surveillance and control. The inexpensive, non-toxic AGO attracts and catches female Aedes aegypti mosquitoes looking for a place to lay eggs. Field trials in which the AGO trap has been installed in most homes in a community have shown it reduces mosquito populations AND transmission rates of infections. AGO traps have been distributed by the CDC to many areas in Puerto Rico, including 90,000 traps distributed in Caguas in early 2017. A partner is now producing the trap for the general public and it’s currently available on the commercial market.
CDC seeks additional commercial partners, both foreign and domestic, with the goal of distributing the AGO trap to as many people and communities as possible worldwide. In addition to scientific publications, the AGO traps have been featured in a number of news articles, including USA Today, the Miami Herald and NBC News.
CDC Photo, CDC NCEZID Puerto Rico laboratory.
There is always some mold everywhere – in the air and on many surfaces. Mold has been on the Earth for millions of years. Molds grow where there is moisture and they can flourish in damp, warm, and humid environments. Some people are sensitive to molds and can be prone to infections or allergic reactions depending upon their immune status.

Vulvovaginal candidiasis, also known as a vaginal yeast infection, is a common condition of women worldwide, with over 70% of women experiencing an infection once in their lifetime. While most candidiasis patients are infected with Candida albicans, the number of non-C. albicans infections have grown steadily in recent years. Importantly, yeast infections caused by non-albicans species are resistant to azole drugs typically prescribed for C. albicans infections, resulting in reoccurrence of non-albicans infections.
In a video , CDC inventor Dr. Christine Morrison discusses Candida infection diagnostics and commercialization efforts which received a 2016 Federal Laboratory Consortium (FLC) Excellence in Technology Transfer award.
CDC’s Kevin Brand discusses the process of licensing the Candida infection diagnostic technology as part of the 2016 FLC Excellence in Technology Transfer award.
CDC’s Dr. Christine Morrison shares brief insights for inventors on the benefits of reporting new discoveries.

“Kennel cough” or infectious tracheobronchitis (ITB) is an acute, contagious respiratory infection in dogs characterized mainly by coughing. Canine ITB is considered one of the most prevalent infectious respiratory diseases in dogs worldwide. Outbreaks can reach epidemic proportions when dogs are housed in high-density population environments such as kennels. Canine ITB can be triggered by a variety of pathogens, including canine influenza virus.

H1N1 influenza emerged in the US in 2009. Within a year, it caused a worldwide pandemic that resulted in an estimated 60.8 million cases, 274,304 hospitalizations, and 12,469 deaths in the US alone. Global estimates of the 2009 H1N1 pandemic indicated that 151,700 – 575,400 people died, with the majority of deaths occurring in Africa and Southeast Asia.

Exposure to lead and other heavy metals remains a public health concern in environments where individuals can be exposed to such metals. Various venues present the danger of skin contamination, including the battlefield, outdoor hunting activities, and exposure from work in industrial settings. The cumulative effects of skin exposure to lead and other heavy metals can lead to organ and renal failure, and adversely impact blood pressure and brain activity.

Rotavirus is a common diarrhea-causing pathogen in children. Prior to rotavirus vaccination availability, rotavirus caused an average of 611,000 deaths per year globally and millions of hospitalizations. Virtually all children were infected by rotavirus by age 5. Rotavirus continues to cause severe diarrhea in infants and young children in the U.S. and globally. The majority of children that have access to adequate medical care survive infection with no significant long-term consequences. However, the number of deaths associated with severe diarrhea, vomiting, dehydration, and shock is staggering and preventive intervention is required.

Syphilis is a sexually transmitted infection that remains a global health threat. The World Health Organization estimates that approximately 10.6 million new cases of syphilis infections are reported annually worldwide. Previously, the only commercially available serological test for syphilis determined lifetime exposure to Treponema pallidum, the bacterium that causes syphilis. This test was not able to distinguish between an active syphilis infection from lifetime exposure to the bacteria.